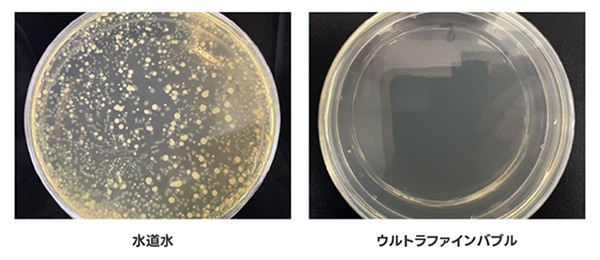

EVIDENCE 実験結果
水の洗浄力を高め、短い時間で
汚れを洗浄
experiment 10 汚れ落ち比較実験

【試験概要】不織布に擬似汚れとしてラー油を一定量滴下。ビーカーに水を加え、20℃で調製。溶液に不織布を浸漬させ、スターラーで一定回転数攪拌した。
【試験品】シバタエンジン ※実使用環境の効果ではありません。使用環境などの条件により効果は異なります。
排水管汚れの残存率減少
experiment 9 排水管の汚れ落ち比較実験


【試験概要】U字配管に擬似汚れ(油分、タンパク質、水など)を塗布し、1日乾燥。タンクに水を溜め、自然排水で流した流水11L/分で10秒間通水して比較した。
【試験品】シバタエンジン ※実使用環境の効果ではありません。使用環境などの条件により効果は異なります。
水垢を抑制し、水垢付着量36.9%低減
experiment 8 水垢付着量実験


【試験概要】ステンレス板に試験水(イオン交換水で5倍希釈した天然水)を0.5h流水、1h停止(乾燥)を繰り返し、100サイクル実施後に水垢(スケール)を比較した。
【試験品】シバタエンジン
【基材】5cmステンレス板 ※実使用環境の効果ではありません。使用環境などの条件により効果は異なります。
洗車の仕上がりが綺麗に
experiment 7 車ボディの汚れ落ち比較実験

【試験概要】車のボディに擬似汚れ(ワセリン、黒絵具)を15×15cmの正方形に塗布。水圧3.0MPa、吐水量8L/min、距離40cm、50秒間洗浄して比較した。
【試験品】シバタエンジン ※実使用環境の効果ではありません。使用環境などの条件により効果は異なります。
水まわりの汚れを軽減
experiment 6 菌の汚れ落ち比較実験
【試験概要】まな板に10mlの菌液(黄色ブドウ球菌・大腸菌)を全体に塗布。それぞれウルトラファインバブル水と水道水で5秒間流水洗浄した後の検体を採取し、培養した。
【試験品】シバタエンジン
【試験協力】愛媛県 水産加工会社様 ※実使用環境の効果ではありません。使用環境などの条件により効果は異なります。
化粧品のクレンジング力アップ
experiment 5 化粧品の汚れ落ち比較実験


【試験概要】擬似皮膚に化粧品(BB&UVクリーム)を塗布し、30分自然乾燥。シャワーを利用して流量10L/min、30秒間洗い流した後、残留した化粧品を比較した。
【試験品】シバタエンジン
【基材】パラフィム(擬似皮膚)
【洗浄距離】20cm※実使用環境の効果ではありません。使用環境などの条件により効果は異なります。
食器洗いの時間を短く、水の
使用量を節水
experiment 4 食器の汚れ落ち比較実験


【試験概要】皿にカレーを塗布し、60分自然乾燥。それぞれウルトラファインバブル水と水道水(温度27℃、流量12.5L/min)で10秒間洗い流した後、残留したカレーを比較した。
【試験品】シバタエンジン
【基材】磁器皿
【洗浄距離】10cm ※実使用環境の効果ではありません。使用環境などの条件により効果は異なります。
肌が潤う、超微細気泡が浸透する
experiment 3 肌水分量変化率実験

【試験概要】皿にカレーを塗布し、60分自然乾燥。それぞれウルトラファインバブル水と水道水(温度27℃、流量12.5L/min)で10秒間洗い流した後、残留したカレーを比較した。
【試験品】シバタエンジン
【基材】磁器皿
【洗浄距離】10cm ※実使用環境の効果ではありません。使用環境などの条件により効果は異なります。
身体を温め、湯冷めしにくい
experiment 2 肌表面温度比較実験

【試験概要】前腕部内側に水道水とウルトラファインバブル水の水流を約2分間あてた後、肌表面温度を比較した。
【試験品】シバタエンジン
【被験者】女7名 ※実使用環境の効果ではありません。使用環境などの条件により効果は異なります。
植物の成長促進
experiment 1 かいわれ大根の成長比較

【試験概要】かいわれ大根の種を各40粒容器に入れ、水を毎日交換して発芽するまで蓋をして日光を遮断。7日後の成長を比較した。
【試験品】シバタエンジン
【期間】7日間 ※実使用環境の効果ではありません。使用環境などの条件により効果は異なります。